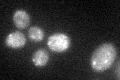
YLR239C
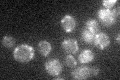
YLR239C

View description
Lipoyl ligase, involved in the modification of mitochondrial enzymes by the attachment of lipoic acid groups
Localization:
Intensity:
Fold change:
Significance:
-
C’ GFP library in SD

mitochondria17.74 -
N' NOP1pr-GFP in SD

mitochondria97.9159 -
N' TEF2pr-mCherry in SD

mitochondria63.5978 -
N' NATIVEpr-GFP in SD

ambiguous,mitochondria24.6608 -
N' TEF2pr-VC and Cyto-VN in SD

#N/A0 -
C’ GFP library in SD+DTT
mitochondria20.271.14No -
C’ GFP library in SD+H2O2

mitochondria19.811.11No -
C’ GFP library in Starvation Media
mitochondria19.971.12No -
C’ GFP library on the background of Pup2-DaMP

mitochondria -
C’ GFP library on the background of CCT mutant

mitochondria19.78391.11463No
